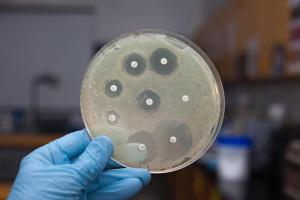

Segíts magadon, hogy csökkentsék a nyomást a népi jogorvoslat
Magas vérnyomás - van egy nagy probléma, tele van súlyos szövődmények. Mivel a magas vérnyomás befolyásolja a véredények, az agy, a szív és a vesék. Minden évben, a betegség halálát okozza több mint egy millió ember egyedül Oroszországban. Ma arra utal, hogy betegségek, amelyek nagyobb valószínűséggel halálhoz vezethet. Nem túlzás azt mondani, hogy ez a csapás az emberiség, mert a magas vérnyomás kíséri minden más ember a bolygón. Ez nem titok, ezért igyekszünk tartani a betegség ellenőrzés alatt: fogadja normalizálása gyógyszerek, csökkenti a nyomást a népi orvoslás. A lehetőségek a hagyományos orvoslás fenntartásában normális vérnyomás mondta a cikkben.

Átfogó kezelés - elengedhetetlen feltétele
Először azt kell kikötni, hogy a magas vérnyomás kíséri sok más betegség - a szívkoszorúér-betegség, cukorbetegség, ateroszklerózis, és így tovább. A magas vérnyomás gyakran okoz szívrohamot és szélütést. És ezért bölcs dolog, hogy vegyenek részt a független cselekvés, és csak próbálja, hogy le a nyomást bármilyen eszközzel megfeledkezve a kezelés a probléma forrását. Állandó orvosi felügyelet, ragaszkodás a követelmények a szakmai a legfontosabb, és csak együtt ezeket a követelményeket csökkenti a nyomást a népi orvoslás. Folk gyógyítók ajánlani főleg herbalism. Ezen túlmenően, számos élelmiszerek, amelyek hozzájárulnak a fenntartásához normális vérnyomás.
Egyszerű emberek jogorvoslatok, hogy csökkenti a vérnyomást
A hagyományos orvoslás is jó az a tény, hogy mindent meg kell rendszerint kéznél. Például minden házban van egy citrom, fokhagyma, tej.

Emlékezzünk rá, néhány egyszerű receptek, amely által csökkentik a nyomást a népi orvoslás. A klasszikus és ismerős kombinációja a magas vérnyomás - fokhagyma és citrom. Két közepes citromhéj és tisztított fej fokhagymát közepes méretű csiszoló őrölni, és töltse ki a két csésze (500 ml) hűvös forralt vizet, sört több órán keresztül. Ezt a készítményt kell tenni egy evőkanál naponta háromszor fél órával étkezés előtt. Egy hónap múlva a belépés egy kis szünetet egy hétig, majd ismételje meg.
Szárított virágok és gyümölcsök galagonya - is ismert orvosság a magas vérnyomás, valamint a fekete berkenye. Vegye infúziók gyógynövények és bogyós gyümölcsök, sört a tea, hanem folyamatosan szüksége van. Kiváló eszköz a nyomás csökkentésére - répa juice. By the way, a saját kezelés és néha túlzásba vinni. Ha csökkenti a nyomást a népi jogorvoslat, meg kell tudni, hogy az erő minden növény. Például állandó recepció homoktövis lekvárt is lehozták alatt a fent említett nyomás, de úgy, hogy a gyengeség kezdődik szédülés. Tehát meg kell emlékezni, hogy legyen óvatos, és minden nap mérni a vérnyomást.

Annak érdekében, hogy az otthoni kezelés
Gyakran csökkenti a nyomást a népi jogorvoslat, gondolkodás, hogy megoldja ezeket a problémákat. Ugyanakkor nem szabad elfelejteni, hogy ez csak a kezét, és hasznos termékek, de nem a fő kezelés. Bár a kezdeti szakaszában a magas vérnyomás hagyományos gyógyszerek hatékonyan okozhat vérnyomás normális. A legfontosabb dolog az, hogy segítsen az egészségre nem lecsap és célirányosan, továbbá, hogy a vérnyomás ellenőrzés alatt. Nem szabad elfelejteni, az egészséges táplálkozás és a kizárás minden menüt ételek és italok, amelyek növelik a nyomást. És persze, a béke és pihenés szükséges, hogy mindenki. Vigyázzon magára.
Aki igazán fedezte fel a penicillint? Tudja, hogy ki fedezte fel a penicillint? Ez az egyik legismertebb történet az orvostudomány. Egy nap 1928-ban, a skót tank.

Mi történik az emberi szervezetben, ami nem a szex? Sex - közel azonos alapvető szükségletek, mint az élelmiszer-bevitelt. Legalábbis kezdtek csinálni, akkor nem hagyja abba. Még ha priderzhivaetes.
